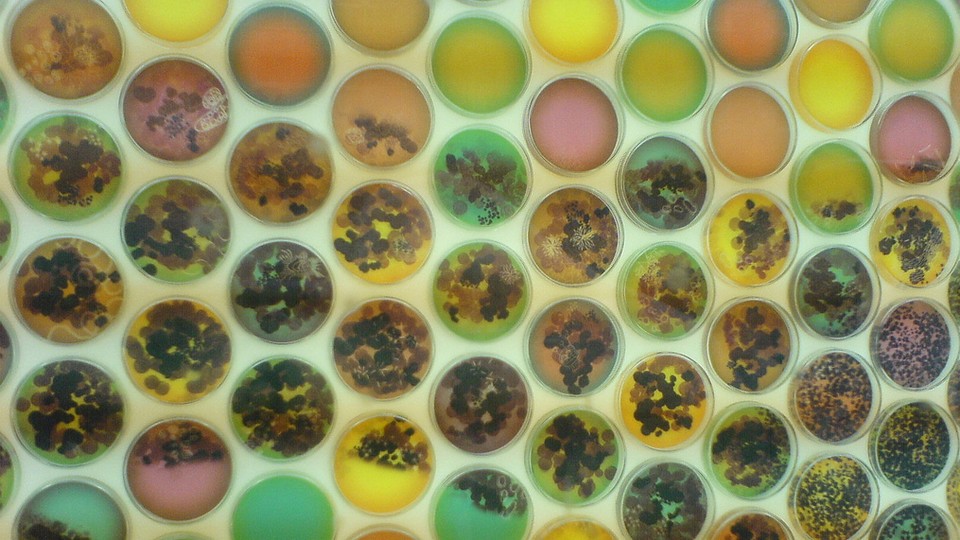

A New Drug in the Age of Antibiotic Resistance
Authorities warn that overuse of such medications has created a public-health disaster. Now, researchers say they've discovered a compound that could slow the clock on the crisis.
Two alarming figures from a report released last month by the U.K. government: By 2050, antibiotic resistance will cost the world a projected 10 million lives and $8 trillion each year.
The report is one more in a growing collection of dire pronouncements about the current state of antibiotics: This past summer, Thomas Frieden, the director of the Centers for Disease Control and Prevention, warned that antibiotic resistance could be “the next pandemic.” In March 2013, England’s chief medical officer urged lawmakers to add antibiotic resistance to the government’s list of civil emergencies, a registry of contingency plans for situations like terrorist attacks and major floods. And last April, the World Health Organization issued its own report, declaring that “a post-antibiotic era—in which common infections and minor injuries can kill—far from being an apocalyptic fantasy, is instead a very real possibility for the 21st century.”
In the U.S. alone, antibiotic-resistant bacteria infect more than two million people each year, killing around 23,000 of them. Meanwhile, scientists are struggling with a losing race against the clock, as bacteria evolve to evade our drugs faster than we can make new ones. But researchers at Northeastern University say they’ve discovered a new antibiotic that may buy us some time. In a paper published today in the journal Nature, they describe teixobactin, a compound they say hasn’t encountered any resistance from the bacteria it attacks.
According to the researchers, teixobactin’s strength lies primarily in its means of attack: “Antibiotics usually hit one defined target, some important protein in the cell,” says Kim Lewis, the lead researcher for the project and a biology professor at Northeastern University. Teixobactin, by contrast, “hits two different targets,” both polymers that build the bacterial cell wall.
“Normally, the way resistance is acquired, there’s a mutation in the [bacterium’s] DNA. A gene changes, so the protein target changes and no longer binds to the antibiotic,” he explains. “These polymers are not coded by genes. They’re made by enzymes, and there’s nothing to mutate. So in a way, they’re immutable targets.”
Once the compound is further developed into a drug, the researchers say, it can be used treat superbugs currently immune to most available treatments, including methicillin-resistant Staphylococcus aureus (MRSA), a type of staph infection common in healthcare settings, and drug-resistant tuberculosis.
Many antibiotics currently in use come from species found in soil—but while the earth was once fertile ground for new compounds, “overmining of this limited resource by the 1960s brought an end to the initial era of antibiotic discovery,” according to the Nature paper, as only around 1 percent of soil organisms can be cultivated in a lab. “So we decided to see if we could tap into uncultured bacteria, the remaining 99 percent,” Lewis says. After developing a method to grow and test soil bacteria in their natural environment, the research team discovered a new species of bacteria, Eleftheria terrae, that produces teixobactin.
The discovery comes at an otherwise frustratingly stagnant time for antibiotic development. Sold for relatively cheap and taken for only a short time, antibiotics are less lucrative than the drugs used to treat chronic diseases. As a result, companies have increasingly focused their attention elsewhere; in 2011, Pfizer, one of only a handful of large pharmaceutical firms working on antibiotic development, shuttered its antibiotic research lab in Connecticut. “The decline in antibacterial drug research and development in the private sector, at a time when serious antibiotic resistant infections are on the rise, is a tremendous public health problem,” Janet Woodcock, the director of the Center for Drug Evaluation and Research, testified before an Food and Drug Administration committee in September.
Teixobactin may encounter bacterial resistance further down the road, Lewis admits, though he predicts it would be at a slower pace than most antibiotics. While widespread resistance to new drugs typically takes anywhere from weeks to years, Lewis anticipates that resistance to teixobacitn may take decades to develop, citing vancomycin, a drug often used to treat MRSA infections, and considered a drug of last resort—one typically saved unless there are no other options. Developed in England in the 1960s, vancomycin, which also targets a bacterial cell-wall polymer rather than a protein, only began to encounter resistance in the 1990s. “So that gives us an idea of how long it will take for resistance to develop to teixobactin,” he says. “It should take more than 30 years.”
But while the lack of resistance may not be permanent, teixobactin’s discovery may inject new energy into a field where need remains far ahead of progress. “The low-hanging fruit has been picked,” infectious-disease researcher Brad Spellberg told the WHO in 2011. “But the concept that we’ve exhausted the pantry is ridiculous.”